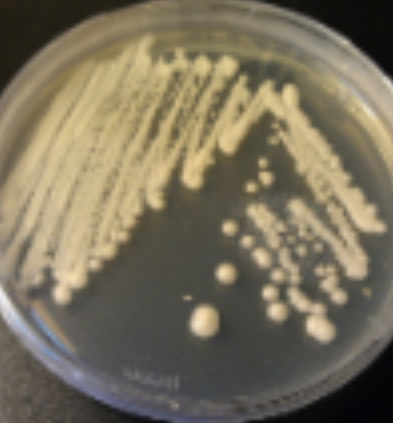
<p>bacterial cultures</p>
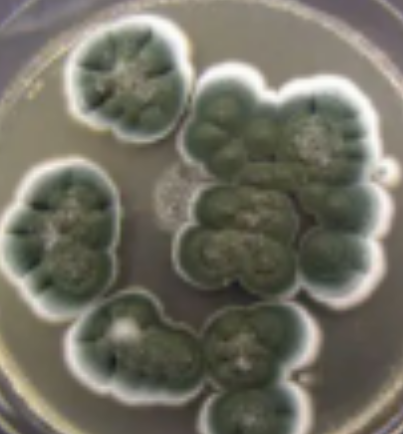
<p>fuzzy </p>

Introduction to the Fungi
1/50
There's no tags or description
Looks like no tags are added yet.
Name | Mastery | Learn | Test | Matching | Spaced | Call with Kai |
|---|
No analytics yet
Send a link to your students to track their progress
51 Terms
How do fungi absorb nutrients?
Directly through the cell wall
What are the two structural forms of fungi?
unicellular yeasts or multicellular filamentous fungi
How do most multicellular fungi reproduce?
spores
What is the body of a multicellular fungi called?
thallus
What is a mycelium
an aggregate of hyphae
What is contained within the cell walls of hyphae?
chitin
What do yeasts look like on an agar plate?
bacterial cultures
What do filamentous fungi look like on an agar plate?
fuzzy
Where do fungal spores origoriginate from?
Hyphae on multicellular fungi
How do yeasts reproduce?
via mitotic budding

What is a saprophyte?
fungi which feeds from decaying matter
What is a biotroph?
fungi which feeds from a living host
What is a necrotroph?
feeds by invading host cells, killing them and obtaining their nurtients
What mechanism do necrotrophs use to obtain nutritents
cell wall degrading enzymes and broad spectrum toxins
What are the 3 phases of fungal feeding?
Hyphal tips release enzymes
Enzymatic breakdown
Products diffuse into hyphae
What two organisms are in lichen?
fungal and cyanobacteria/green alga
What two organisms are in mycorrhiza?
fungi and plant roots
What is the role of fungi in lichens?
Increases the ability for alga/bacteria to absorb mineral salts and water
What is the role of the cyanobacteria/alga in lichen?
Supplies food to fungus via biproducts of photosynthesis
What is the role of the plant in mycorrhizas?
nutrition for the fungus
What is the role of the fungus in mycorrhizas?
Supplies the plant with minerals and water contained in soil
Where does the antibiotic penicillin come from?
The filamentous fungi Penicillum
On what hosts do pathogenic filamentous fungi work best?
immunocompromised individuals
At what temperatures do fungi thrive?
ambient temperatures
thus fungal infection typically external
What is a fungus on skin, hair or nail beds called?
dermatophyte
What fungi is behind athletes foot
tinea
What is the purpose of vacuoles in yeast?
breaking down proteins, storing nutrients and maintaining homeostasis
How do most yeasts reproduce?
asexually via budding
What are the products of fermentation of glucose?
ethanol and CO2
What is a pseudohyphae?
What is candidiasis?
An infection causes by overgrowth of the naturally growing Candida fungi
What causes candidiasis
off-balance of the microbiome
At what temperatures do dimorphic fungi transition?
convert between hyphae (22–25°C) and yeast (37°C)
What is upregulated in the yeast phase of dimorphic fungi?
genes involved in disrupting host immune defense
How do dimorphic fungi create disease?
Inhaled as spores from multicellular forms, develop into yeast in the body due to temperature
What is histoplasmosis
A dimorphic fungi
Common in soils around bird and bat droppings
Risk of complications in immunocompromised
What are true fungi?
Eumycota
Apart from filamentous, what can multicellular yeasts be called?
mold
What is the phospholipid bilayer in fungi made of?
ergosterol
What are the two main components in the fungal phospholipid bilayer
chitin synthase, glucan synthase
From bottom to top, describe the structure of a fungal cell wall
phospholipid bilayer, chitin, glucan, mannoproteins
What macromolecule is glucan?
polysaccharide
What are the three genera of filamentous fungus?
Aspergillus, Penicillium, and Rhizopus
What is unique about the filamentous fungi genera aspergilus
What is unique about filamentous fungi genera penicillum
What is unique about filamentous fungi genera Rhizopus
What is aspergillus
a pathogenic fungus
causes pulmonary disease via inhalation of spores
What are the pseudohyphae of candiada albicans
What is invasive candidiasis?
What is mycoses
a fungal infection
What is the word to describe a disease having spread throughout the body
disseminated